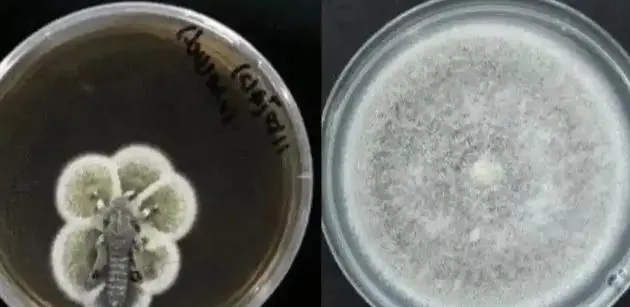

信息来源于webMD、earthobservatory、Medium、中国科学院、科普中国。
关于蝗虫我们大部分人对蝗虫的认知都很浅,它们是小时候草地里的玩伴,给它们后腿绑绳子,一下就能拉断腿;是夜市里最引人侧目的油炸食品,你和朋友总是千方百计想要骗对方吃,结果看到价格瞬间冷静······基本上都算是美好的回忆。

但对农业区的人来说,蝗虫就恐怖的“天灾”!蝗虫作为农业害虫的历史基本上从人类开始种植农作物的时候就开始了。已经这么这么久了,人类却至今都没办法完全解决这个问题,虽然在我国的现在,它们好像没啥存在感,但你不知道上个世纪我国的研究者跟它们斗得多凶。
目前已知全球有超1万种的蝗虫!作为一种古老的昆虫,它们本身确实得天独厚,被称为“虫中之皇”!这个有点夸张的称呼不是单指它们成群后的毁灭力,其个体本身也足够强大。

小时候抓到蝗虫非常喜欢给它们喂东西,不是我心善,是我很喜欢看它们用那个咀嚼式口器吃叶子的画面,它们的口器像钳剪,瞬间就能切碎植物,感觉吃饭效率非常快。它们的后足力量惊人,一瞬间就能跳得很远,能有效逃离没有网兜的野生天敌。为了保持超强运动能力,它们的身体两侧设计出了很多气门,统统都可以帮助其呼吸空气!持续的供氧成为了强大动力的基础。复眼能提供非常大的视野,触角也能敏锐感知空气中的化学信号。

说完了硬件上的,不得不再说说软件上的。
你肯定见过非常多不同颜色的蝗虫,其实有可能它们都是同一种!这是因为它们的体色会根据环境的湿度、温度和同类的密度来自己改变颜色,这就是伪装色了。而且它们如果意识到同类数量增加,其后腿经常被同类蹭到后,它们就会改变激素水平,使得其飞行肌肉的代谢效率提升,能进行远距离的移动。

超强的繁殖力是不可或缺的,一只蝗虫一次可产卵上百粒,一生可以多次产卵。听起来不多,但是它们属于不完全变态昆虫,卵到若虫然后到成虫,直接跳过蛹期,大大缩短了世代时间。而且它们会将虫卵深埋地下,提供了较高的保护,保证了成活率。

蝗虫的适应性也是非常恐怖,它们几乎遍布了除南极以外的所有大陆,说明其对高温、干旱和饥饿都有很强的耐受力。

战斗力不是关键,光看如此强大的软硬件,难怪蝗虫被称为“虫中之皇”。
恐怖的蝗灾蝗灾就是蝗虫成群侵袭农作物的情况。能被称为“蝗灾”,可不是几百只就能算的,起码得是千万只的级别!在不断侵袭的过程中,它们的数量甚至会不断增加,最终达到每平方公里超过2亿只的级别,结合上面说过的超强觅食效率,这样的蝗虫群一天就能吃掉相当于 87500 人一天所吃掉的粮食量。

蝗灾基本上都是铺天盖地的,能覆盖数平方公里的农田,如果你身处其中,会发现蝗虫的密度甚至阳光都能被遮挡,它们威胁到全球多达20%的陆地面积。
不管国外的,就说咱们国内。

根据《中国飞蝗生物学》的统计,在我国近2000多年的历史中,有记录的大规模蝗灾发生了804次!也许很久远的记录不够准确,但进入20世纪后的案例就数据明确了。1931年苏皖两省损失1.3亿银圆,原因是江淮水患后爆发的蝗灾;1942年河南爆发恐怖蝗灾,3个月内使得河南小麦种植区绝收率达到87%!于是饥荒就发生了;1951年河北黄骅县的蝗灾使得全县12万人出动除蝗虫,然而依然抢救不回来1.2万吨的粮食损失!

进入现代后,我国依然偶尔爆发蝗灾,但危害却小了很多。这离不开上个世纪我国研究者们的努力。
应对蝗灾为了养活这么多的人口,农业是最关键的,然而基本上3年就爆发一次的蝗灾简直就是比海外势力还强大的绊脚石。于是新中国成立后,国家立刻就安排将蝗灾的防治当成是国家战略的一部分。

在1951年,国家出台了《关于防治蝗蝻工作的紧急指示》,标志着“全民除蝗”的开始。
在此期间,众多的学者都竭尽所能出力,其中当属生态学家马世骏的各种举措无疑是最有效的。

1952年,马世骏提出了"飞蝗发生地类型理论",这是从根本上找到了蝗虫爆发的原因,他认为"水旱交替是蝗虫滋生的温床"。这个理论在当时是假说,但现在已经被认为是科学基础了!

根据这个理论,马世骏建议通过兴建水利工程和垦荒来改变蝗虫的产卵的环境,国家对其相当信任,事实证明,这份信任没有被辜负!
垦荒可以是种地,也可以是其他的产业,比如水产养殖业。1954年,马世骏在山东微山湖开始了"蓄水养鱼抑蝗"工程,将12万亩蝗虫的潜在繁殖地给改成水产养殖区,结果在此后三年内,山东的蝗虫受灾面积减少了40%!

这真的非常巧妙,以往都是靠杀虫剂解决蝗虫,效果有限还可能存在潜在危害。如今靠着修建水利和扩大生产,不但使得经济发展,还有效减少了蝗虫的数量!类似这样的举措实行了10年到了1960年后,我国的蝗虫受灾面积相比于1951年减少了58%。
马世骏团队被国务院授予"治蝗先锋"的称号。
治理的方法以及很明确了,接下来就是不断提高技术去加强效果。1985年中国农科院研发了微孢子虫(Nosema locustae),这些玩意儿感染蝗虫后,会导致其行动能力下降,产卵量骤减,感染率能达到83%。
生物防治也相当有效,1988年新疆艾比湖湿地引入10万只粉红椋鸟,这些虽然是外来物种,但是是经过挑选的,不会影响本地生态,但却能有效控制蝗虫的数量。它们一天能吃上百只蝗虫,经过检验,粉红椋鸟使当地蝗灾发生率下降76%。

此时的马世骏已经70多岁了,但他依然在抗战蝗虫的第一线,他通过将气象数据跟蝗虫生物学结合,研究出了一套"蝗虫种群动态模型",能够提前预知蝗灾的爆发。你的长辈肯定知道1991年华北的特大蝗灾,如果不是马世骏凭借模型数据提前42天发出预警,当时的受灾肯定更严重,42天的时间,使得河北、山东两省减少粮食损失23万吨。

1991年5月30,马世骏在河北省丰润县境内不幸因车祸罹难殉职。
他的一生波澜壮阔,年轻曾因参加学生抗日救亡活动收到迫害;长大后在国外留学期间替美国农业部的玉米螟生物生态学及防治研究做出贡献。面对美国的挽留,他毅然决然回国拯救中国老百姓的粮食,还为我国防治蝗虫提供了最坚实的基础。

配配网提示:文章来自网络,不代表本站观点。